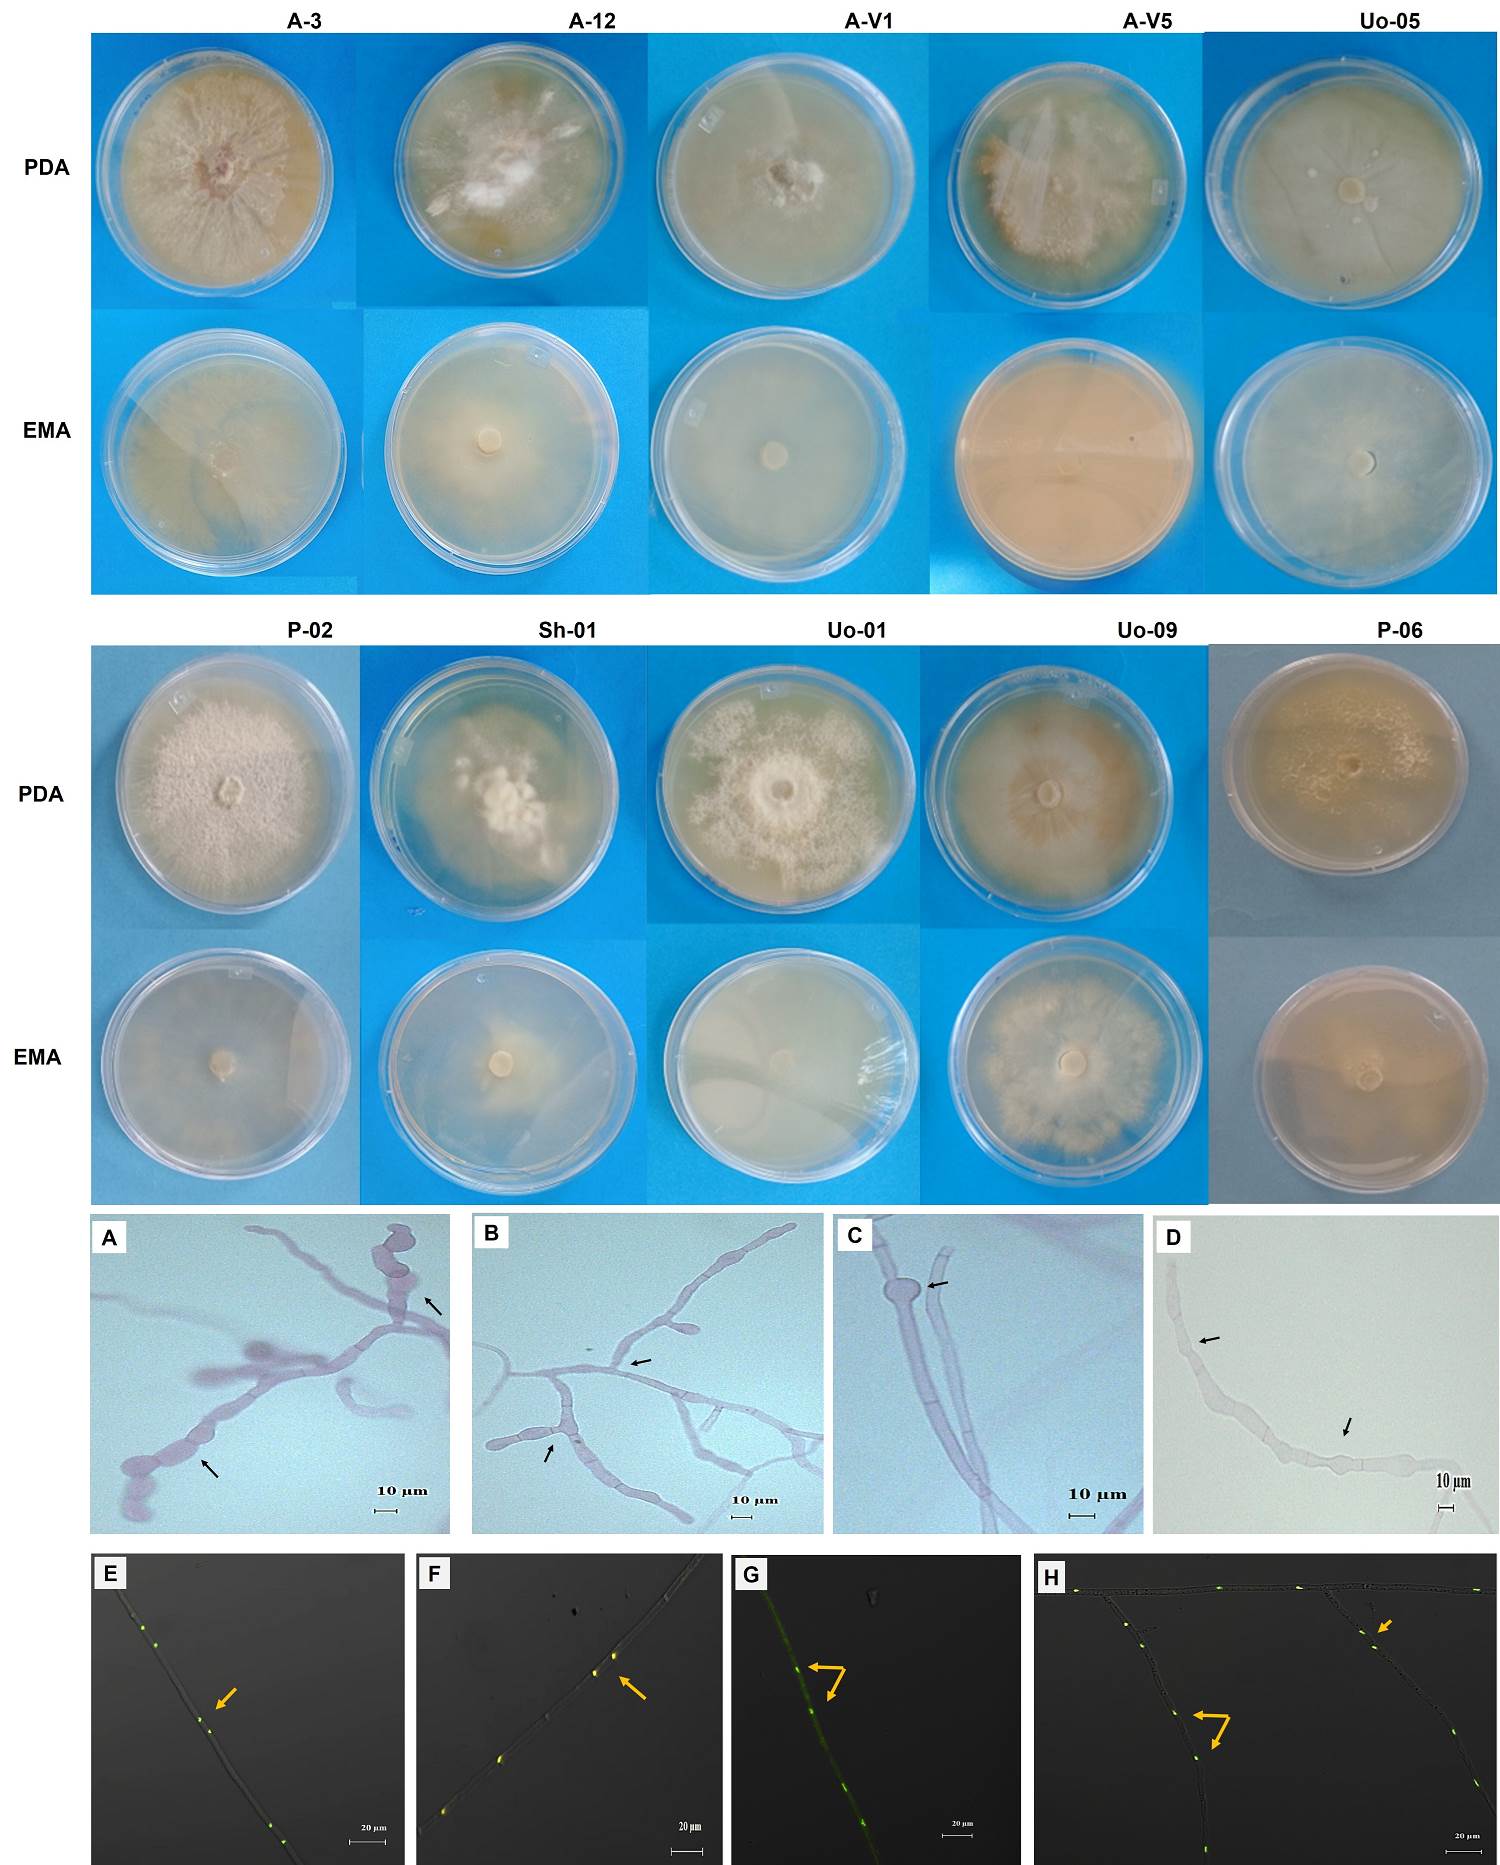

Mexico has been recognized as the center of origin and diversification of vanilla, specifically in the north of Veracruz, where it was domesticated by the Totonac people in pre-Hispanic times (Lubinsky et al. 2008, Shinga et al. 2008). Mexico is one of the top three producers of vanilla worldwide, contributing nearly 8 % of the world’s supply (543 t), surpassed only by Madagascar (44 %, 3,000 t) and Indonesia (23 %, 1,600 t). In Mexico, the state of Veracruz- specifically in the regions of Papantla, Tecolutla, and Gutiérrez Zamora- accounts for 76.4 % of the country's production, followed by Puebla (12 %) and Oaxaca (10 %) (SADR 2024). The primary export countries are the USA (1,807 t), France (1,081 t), and Germany (711 t).
In the Totonacapan region, vanilla is still cultivated using the traditional system, which involves using the disturbed tropical forest “acahual”, where plant communities regenerate. This cultivation system involves a variety of native trees that act as “tutors” for the vanilla vines. This preserves the biocultural diversity of the Totonac people’s cultivation practices (Velázquez-Rosas et al. 2024). However, due to land use changes and landscape alteration, vanilla cultivation has evolved into several agroforestry systems: a) citrus-associated system: this is one of the most common practices, were vanilla is cultivated alongside orange trees (Citrus sinensis L. ), offeringthe dual benefit of both vanilla and citrus production; b) pichoco tree (Erythrina spp.) and/or cocuite tree (Gliricidia sepium): in this method, the vanilla vines are supported by these trees, which provide good shade and organic matter; however, both are susceptible to pests and diseases; c) shade-house: this semi-technified cultivation system uses a mesh that provides 50 % darkness to the plants, with live tutors (such as Erythrina spp.), or inert supports. This system is increasingly popular due to the lower cost of materials (Barrera-Rodríguez et al. 2011, Sánchez-Ramírez 2022) (Table 1).
Table 1 Crop systems for vanilla culture in Papantla, Veracruz, México.
| ACAHUAL (traditional) | UNDER ORANGE TREE | SHADE HOUSE | PICHOCO TREE | |
|---|---|---|---|---|
| Type of cultivation | Agroforestry | Policulture | Technified monoculture | Monoculture |
| Support | Erythrina spp., Litsea glaucescens, Tabernaemontana alba, Bauhinia forficata, Glyricidia sepium Jacq. | Citrus sinensis L. | Erythrina spp., Saurauia yasicae, Tabernae montana alba | Erythrina spp. |
| Pests and diseases | Fungi and red bug Stem rot and root | Pest in support post | Fungi stem rot and root | Fungi stem rot and root |
| Pest and disease control method | Organic | Organic and FoleyR* | Organic and FoleyR* | Organic |
| Irrigation | No | No | Yes | No |
| Fertilizer | Yes | Yes | Yes | Yes |
| Yield (Kg/ ha) | 50-500**, >50*** | 500-2,500**, >500*** | 5,140**, 3,400*** | 1,000- 4,000**, >1,000*** |
| Advantages | -Conservation of native species -Sustainable production methods -Promotes the quality of the fruit in its aromatic content |
Increases at double the economic value | Better yield production | Soils with more organic content |
| Disadvantages | -Susceptibility to fungal diseases -Low yield -More vulnerability to environmental damages |
-Large input of agrochemicals -Increased frequency of citrus pests |
-Unavailable for all producers | -Plagues in phorophytes. -More vulnerability to environmental damages |
*Clorpiriphos (FoleyR), organophosphate insecticide. **Barrera-Rodríguez et al. 2009, Hernández-Hernández et al. 2010b, Bautista 2014, Trinidad García 2014, Sánchez-Ramírez 2022. ACAHUAL (Traditional management): forest composed mainly of secondary vegetation, UNDER ORANGE (Citrus sinensis L.) and PICHOCO (Erythrina spp.) trees both tutors for vanilla cultivation, SHADE HOUSE: semi-technified cultivation system with shadow mesh.
Nowadays, vanilla production is critical in the region due to the low yields in recent years, which reached the minimal values reported for the region at the beginning of the century (Hernández-Hernández 2010a Barrera-Rodríguez et al. 2011, SAGARPA 2019). However, production has been declining hastily due to several factors, including the abandonment of the crops due to a fragile organization of producers (Barrera-Rodríguez et al. 2014), organized crime (Jaramillo et al. 2012), management problems (Barrera-Rodríguez et al. 2011, Alejo-Viderique et al. datos no publicados), migration causing the loss of ancestral cultivation knowledge, and environmental factors that lead to diseases and pests exacerbated by climate change (Santillán-Fernández et al. 2018). In its natural habitat, V. planifolia requires pollinators for fecundation. However, for its cultivation, manual fertilization is needed, a technique developed years ago to allow vanilla to be grown outside of its native distribution region (Bory et al. 2008). This technique, together with clonal vegetative propagation (by cuttings), has resulted in low genetic diversity among vanilla cultivars worldwide, which has made it difficult to cope with environmental conditions, diseases, and climate change (Bory et al. 2008, Chambers et al. 2021, Hu et al. 2019, Lubinsky et al. 2008). It is important to note that in addition to very limited genetic variability in this crop, since its propagation is clonal by cuttings; therefore, the production of seedlings from the germination of seeds that come from manual pollination is inexistent (Schlüter et al. 2007). As a result, vanilla crops are very susceptible to the attack of pests and diseases (Menchaca et al. 2011, Ramos-Castellá & Iglesias-Andreu 2022).
Mexico should strive to produce better-quality vanilla rather than competing in quantity for its industrialization and technification with countries like Madagascar, the world’s leading producer of this crop (Lubinsky et al. 2008, Barrera-Rodríguez et al. 2014). To achieve this, it is necessary to analyze how traditional (ancestral) cultivation promotes sustainable vanilla cultivation, as it must be consistent not only with local resources and traditional knowledge, but also with low input and local possibilities. To this end, solutions must be sought to the current problems that most affect vanilla production concerning its per se cultivation, among them, diseases caused by fungi such as F. oxysporum f. sp. vanillae (Hernández-Hernández 2010b, Adame-García et al. 2015, Casillas-Isiordia et al. 2017, González-Reyes et al. 2020). This is a saprophytic fungus of cosmopolitan distribution that infects the plant through lesions on the root’s surface and causes a disease known as stem and root rot. While this disease can occur year-round, it is more severe during the rainy season when the increased humidity favors fungal growth and can cause crop losses of up to 67 % (González-Reyes et al. 2020). Improper crop management includes removing diseased plant tissues and then throwing them into the same cultivar, thus reinoculating the fungus in the soil, which could survive in it (Adame-García et al. 2015, Hernández-Martínez et al. 2020, Alejo-Viderique et al. unpublished). Yet, the soil also harbors beneficial microorganisms that can be used to improve the health of vanilla plants (Chen et al. 2023), such as mycorrhizal fungi (mainly Tulasnella spp. and Ceratobasidium spp.) and bacteria of the genera Bacillus, Rhizobium, Mesorhizobium, and Pseudomonas, which help fix nitrogen, improve nutrient uptake, and promote plant growth (Wanjofu et al. 2022, Díaz-Urbano et al. 2023). Some of these microorganisms are the consortium of mycorrhizal fungi, for the better plant nutrition, resistance to water stress, and act as a protective biological barrier to the attack of pathogenic fungi. In fact, it could possibly make the fruit quality higher (Gamboa-Gaitán 2014, Bleša et al. 2021, Manrique-Barros et al. 2023). Global research on the use of these microorganisms for biofertilizers has been limited because foreign producers prioritize investments in biotechnology for inorganic fertilizers and advanced agricultural systems, driven by the high demand for these products, rather than traditional methods (Egamberdieva et al. 2015, Maitra et al. 2021, Gamage et al. 2022). For these reasons, the search for beneficial microorganisms that provide nutrients to plants, promote plant growth and resistance to biotic and abiotic factors -known as bioinoculants- is crucial. Bioinoculants are urgently needed to develop highly competitive certified organic crops as local resources to fully or partially replace the use of chemical fertilizers (Armenta-Bojórquez et al. 2010, Abhilash et al. 2016, Maitra et al. 2021). This, in turn, creates more sustainable agricultural systems to increase production without compromising human and animal health, and preserve essential resources such as soil, water, and diversity (Armenta-Montero et al. 2022, Díaz-Urbano et al. 2023). V. planifolia crops, specific studies have been conducted with several microorganisms like Trichoderma harzianum, Bacillus megatherium, and Pseudomonas fluorescences used alone or in consortia as bioinoculants to evaluate the effect of rooting and growth of cuttings, showing positive effects (Murthy et al. 2010). Moreover, mycorrhizal fungi of the genera Ceratobasidium and Tulasnella have also been used for biocontrol against Fusarium (spp.). All these studies contribute to a better understanding of interactions between tropical orchids and their microbiota (Manrique-Barros et al. 2023). The search for bioinoculants is urgent to develop highly competitive certified organic crops as local resources; however, this must start by the knowledge of the in situ mycorrhizal partners.
Most orchids are known to associate primarily with mycorrhizal fungi of the anamorphic genus Rhizoctonia (Basidiomycota) (Kristiansen et al. 2001, Rasmussen 2002, Rasmussen & Rasmussen 2014). This group of fungi is characterized by the absence of reproductive structures in the sexual stage (anamorph), the presence of bifurcations that generate right angles with respect to the main hypha, and a constriction at the point of bifurcation with an adjacent septum, which makes these key criteria for identification (González García et al. 2006, Porras-Alfaro & Bayman 2007). Additionally, monilioid cell formation, hyphal width and length, and number of nuclei per cell are also used for characterization (Andersen 1996, Rachanarin et al. 2018). The association with mycorrhizal fungi is decisive for their establishment, survival, distribution, and development of orchids (Li et al. 2021, Rasmussen & Rasmussen 2014), as these fungi play an important role in nutrient and water uptake in terrestrial as well in epiphytes species (Zotz & Hietz 2001, Yoder et al. 2010, Martos et al. 2012). Additionally, it is worth noting that mycorrhizal fungi form masses of intracellular hyphae within the root, known as pelotons (Currah et al. 1997). Unlike orchids from temperate regions, the mycorrhizal relationships of terrestrial orchids from tropical zones are largely unexplored (Pereira-Liparin et al. 2005). In vanilla, there is little information on mycorrhizal fungal communities in association with roots of native cultivars (Porras-Alfaro & Bayman 2003, 2007, Bayman et al. 2011, González-Chávez et al. 2018, Johnson et al. 2021). Ceratobasidium (anamorph Ceratorhiza), Thanatephorus (anamorph Rhizoctonia), and Tulasnella (anamorph Epulorhiza) have been reported as common mycorrhizal fungi of vanilla roots (Porras-Alfaro & Bayman 2007), with the latter genus being the most abundant in vanilla crops (Petrolli et al. 2024, Hellequin et al. 2024). This highlights the ability of V. planifolia to associate with different types of fungi depending on its environment (Rasmussen & Rasmussen 2014, Hellequin et al. 2024). The diversity in vanilla cropping systems where different phorophytes (support tree for epiphytes) are growing, as well as differential management practices (Table 1), can provide distinct nutrients and microenvironmental niches for both plants and fungi. This, in turn, promotes the diversity of the microbial community (Johnson et al. 2021, Petrolli et al. 2024). The mycorrhizal association with V. planifolia is facultative during the photosynthetically active stage, and the plant’s nutritional status is favored through the carbon exchange that occurs when it degrades the fungal hyphae (Porras-Alfaro & Bayman 2007). The objective of this study was to identify mycorrhizal fungi from the four cultivation systems of V. planifolia used by Totonac producers utilizing a combination of molecular and morphological techniques. In addition, the phylogenetic relationship of the mycorrhizal fungi isolated from vanilla grown in these traditional systems was analyzed with those reported in the literature for other cultivars worldwide.
Materials and methods
Study area. Four different vanilla management systems were sampled in the locality of Papantla Veracruz, Mexico (Figure 1). The characteristics of each management system are summarized in Table 1.

Figure 1 Locations in Papantla, Veracruz, Mexico, where the four cropping systems of Vanilla planifolia were sampled.
Root sampling. Prior diagnosis of the mycorrhizal status of vanilla plants in the study systems; it was found that the roots with the highest colonization percentages were the terrestrial secondary roots, while the aerial roots showed very little to no colonization. Consequently, the sampling consisted of taking 10 secondary terrestrial roots from different plants distributed along each cropping system collected during the rainy season of August 2022-2023 (Figure 2A-F). Colonization characterization was performed and segments with abundant mycorrhiza and without peloton degradation were selected for isolation.

Figure 2 Vainilla planifolia cultivation systems in Papantla, Veracruz. (A) Acahual, (B) under orange tree, (C) shade house, (D) associated with pichoco tree, (E) sampling of terrestrial roots, (F) presence of mycorrhizal pelotons in terrestrial root (red arrow) and aerenchyma around the vascular cylinder (black arrows), (G and H) hyphal growth from the pelotons for isolation. Bar 100 µm.
Mycorrhizal isolation and morphometric characterization. The mycorrhizal segments were disinfected with 10 % sodium hypochlorite for 10 min, followed by a wash with sterile distilled water, a wash with 70 % ethanol for one min, and yet another wash with sterile distilled water. The pelotons were removed from the root tissues of each segment and seeded on Fungal Isolation Medium (FIM) (Clements et al. 1986), as well as on water-agar. Plates were observed daily for growth and pelotons free of contamination and with emerging hyphae were subcultured onto Potato-Dextrose-Agar medium (PDA 39 g, pH 6.8; DIBICOⓇ, Mexico) (Figure 2G-H). In this medium, the colony was allowed to grow, and they were subcultured in the same medium in case it expressed characters of fungi associated with mycorrhizae formers (Rhizoctonia anamorphs). Next, their morphometry was characterized by quantifying the growth rate on PDA and malt extract agar (MEA 15 g, pH 5.0; DIBICOⓇ, Mexico) (Tom & Raper 1945), appearance of colonies, meristics of hyphae and monilioid cells, nuclei staining (Meinhardt et al. 2001), and reaction to polyphenoloxidase in tannic acid medium which allows differentiation between families such as Ceratobasidiaceae and Tulasnellaceae. (Davidson et al. 1938, Zelmer et al. 1996).
Phylogenetic analysis. Once the Rhizoctonia anamorphic characters were confirmed, the cultures were selected for sowing in liquid medium Potato-Dextrose-Broth (PDB, 24 g, pH 6.8, Difco™, USA) for massing. From there, subsamples were taken for DNA extraction with the Promega WizardⓇ kit, according to the manufacturer’s characteristics. DNA was also extracted from root pelotons to identify mycorrhizal fungi that could not be isolated. Samples of mycorrhizal root explants -each approximately 0.5 cm thick- were also extracted. The extracted DNA was used for amplification of the ITS region with the ITS1-4, ITS1-4 Tul oligos (Gardes & Bruns 1993, Taylor & Mccormick 2008). PCR conditions were 95 °C for 2 min, 35 cycles of 95 °C for 1 min, 56 °C for 1 min, and 72 °C for 1 min elongation time 72 °C. For ITS1-4 Tul, they were 96 °C for 2 min, 35 cycles of 94 °C for 30 s, 54 °C for 40 s and 72 °C for one min, elongation time 72 °C. PCR products were sent for sequencing by capillary electrophoresis to Macrogen, Inc. The sequences obtained were visualized and edited in the program GeneiousⓇ version 11.1.5. Alignment was carried out in the program SeaView Version 4 (Gouy et al. 2010). The construction of the phylogenetic tree based on the ITS1-4 regions was performed by Maximum Likelihood trees (Felsenstein 1981) and Tamura Nei (Tamura & Nei 1993), using the program MEGA X version 10.2.6 (Kumar et al. 2018). Some of the sequences obtained corresponded to endophytes of Fusarium spp.; therefore, we proceeded to perform their phylogeny and associate it with cultivar management.
Results
Morphological and physiological characterization of isolates. During the isolation, pelotons with oval and spherical morphotypes were observed in the system under orange trees (Figure 2 G-H). A total of 74 isolates were obtained, of which 10 were mycorrhizal fungi (isolation efficiency 13 %). The cultivar systems that presented the greatest difficulty in isolation were the shade house and the acahual (traditional management system) in the Cuyuxqui community (Figure 1). In the latter, no isolates could be obtained (the resulting sequences were directly obtained from the pelotons in the roots). This may be due to the presence of fungi, such as Fusarium oxysporum, in the soil of the cultivation systems, particularly in the acahual and shade house systems; additionally, plants with lesions such as stem and root rots were observed. The description of the 10 strains with characteristics of the anamorph Rhizoctonia is presented in Table 2. The appearance of the colonies (Figure 3) was of strains with slow growth (< 4 mm per day), submerged mycelium, some were slightly waxy (Uo-01, A-3, A-12, P-02 and P-06) with soft aerial mycelia without forming rings like strains A-V1, A-V5 and Sh-01. The hyphae measured on average 3.6 µm, and some strains presented monilioid cells in digitiform form (A-3, A-V1, Uo-05 and Uo-09) (Figure 3A-B) with other characteristics (Figure 3C-D). All of them presented binucleate hyphae (Figure 3E-H) and were negative to tannin degradation. During the isolation process, there were mostly strains corresponding to morphological characteristics of Fusarium. These isolates presented a white cottony appearance and -as they aged- they turned purple or brown with pink-brown pigmentation on the reverse side. Microconidia and chlamydospores were also observed in the morphological structure, so some were selected for molecular identification (Figure 4).
Figure 3 Morphological characteristics in culture medium PDA and EMA, and morphometric characteristics of Tulasnella spp. strains isolated from Vanilla planifolia of four cultivars from Papantla, Veracruz, Mexico. A-acahual; U-under orange tree; Sh-shade house; P-pichoco. (A) Digitiform monilia of isolated Tulasnella A-12; (B) Monilioid cells and 90° angle of growth of Tulasnella A-V1; (C) intercalary spherical structure observed in hyphae of Tulasnella Sh-01; (D) Digitiform monilia with a “waist” of Tulasnella Uo-09. Bar 10 µm; (e-i) Binucleate hyphae of Tulasnella strains Uo-01, A-3, Sh-01, Uo-01 and Uo-09. Bar 20 µm.
Table 2 Morphological characters of Tulasnella spp. isolates from Vanilla planifolia from Papantla, Veracruz, Mexico.
| Type of cultivation | Isolates | Colony | Color | Growth rate at 25 °C (mm/d) on: | Basal septum | Hyphal width | Monilioid cells (µm) | ||
|---|---|---|---|---|---|---|---|---|---|
| PDA | EMA | (µm) | (µm) | Width | Length | ||||
| Acahual | A-3 | Submerged flat | Cream to brown | 3.8±1.54bc | 2.51±1.08bc | 3.76±0.55abc | 3.43±0.41abc | 7.78±1.06*a | 39.04±9.35a |
| A-12 | Flat | Cream to white | 4.02±1.04abc | 3.35±0.55abc | 3.44±0.56bc | 3.99±0.47ab | G | ||
| A-V1 | Flat | Cream to white | 3.29±0.65*c | 2.91±0.43*c | 3.33±0.91bc | 3.70±0.54ab | G | ||
| A-V5 | Flat | Cream to white | 3.2±0.93abc | 4.13±0.86abc | 3.12±0.55*c | 3.8±0.45ab | NO | ||
| Under orange tree | Uo-01 | Sumerged flat | Cream to white | 3.12±1.1bc | 3.02±1.12bc | 3.34±0.85bc | 4.20±1.18*a | NO | |
| Uo-05 | Velvety flat | Cream to white | 3.97±0.83*a | 4.5±1.58*a | 3.35±0.61bc | 3.18±0.65bc | 3.18±0.65b | 28.99±3.69*b | |
| Uo-09 | Flat | Cream to white | 3.43±0.52bc | 2.56±1.5bc | 3.83±0.99bc | 4.11±0.81*a | 8.95±1.28*a | 26.75±6.97*b | |
| Shade house | Sh-01 | Sumerged flat | Cream to white | 1±0.25*d | 0.97±0.24*d | 5.96±1.24*a | 3.99±0.48ab | NO | |
| Pichoco tree | P-02 | Sumerged flat | Cream to white | 4.05±0.84ab | 3.7±1.07ab | 3.18±0.39bc | 3.47±0.32abc | G | |
| P-06 | Flat | Cream to white | 3.43±1.04abc | 3.42±0.95abc | 4.36±1.07*b | 2.73±0.42*c | NO | ||
Asterisks represent significant differences 𝘱 ≤ 0.05; letters show pairwise comparisons according to Tukey's method with confidence value of 95%; NO= not observed, G, growing. Acahual (Traditional management): forest composed mainly of secondary vegetation, Under orang (Citrus sinensis L.) and Pichoco (Erythrina spp.) trees both tutors for vanilla, Shade house: semi-technified cultivation system with shadow mesh.

Figure 4 Colonial growth of Fusarium oxysporum f. sp. vanillae Sh-04 isolated from Vanilla planifolia roots of the shade house system in Papantla, Veracruz, Mexico. (A) Front, (B) back, (C) microconidia (black arrow), chlamydospores (red arrow). Bar 50 µm.
Phylogenetic analysis. The phylogenetic analysis is presented in Figure 5, which shows the distribution of the 16 sequences obtained, of which 6 were directly from mycorrhizal root explants (identified with *), and 10 sequences were obtained from isolates. It was observed that the sequences are grouped in two main clades associated with fungi identified for Vanilla planifolia and V. poitaei from Puerto Rico (Gamboa-Gaitán 2014). These sequences show a 99 % similarity, indicating that they are likely the same species obtained from the system under orange tree (strains Uo-01 and Uo-03*). Strains P-06, U0-09 and A-10* in this same clade are associated with a 99 % similarity to a Tulasnella identified from a terrestrial orchid from Reunion Island (Kumar et al. 2018). Sequence Sh-04* is found in the clade of a Tulasnella isolated from V. planifolia from Puerto Rico, and sequence Sh-07* is found in the clade of a Tulasnella isolated from V. poitaei also from Puerto Rico (Porras-Alfaro & Bayman, 2003) with the same similarity as the previous ones. The remaining isolates form a distinct clade supported by a bootstrap value of 96.0. This clade consists of sequences from the four culture systems, seven isolates, and two tissues (Sh-03 and A-07). The percent similarity to Tulasnella AP-27, isolated from V. poitaei from Puerto Rico, ranged from 94.8 to 97.4 representing the closest clade.

Figure 5 Phylogenetic tree based on the ITS regions of strains of the genus Tulasnella isolated from various cropping systems of Vanilla planifolia from Papantla, Veracruz. The color indicates the cropping system from which they were isolated: blue is acahual (secondary vegetation of tropical forest); orange is under orange tree (Citrus sinensis); green is shade house and purple is pichoco (Erythrina spp.); * indicates that the sequences were obtained directly from mycorrhizal roots. The analysis was performed by maximum likelihood with bootstrap replicates = 1,000.
Figure 6 shows the phylogenetic analysis of seven selected Fusarium strains, where five of the strains correspond to F. falciforme, and strains Sh-04 (shade house) and A-01 (acahual) correspond to F. oxysporum f. sp. vanillae (99.99% similarity) -the main pathogen associated with stem and root rot disease (Pinaria et al. 2010, Adame-García et al. 2015).

Figure 6 Phylogenetic tree based on the ITS regions of strains of the genus Fusarium and strains isolated from three cropping systems of Vanilla planifolia from Papantla, Veracruz. The color indicates the cultivation system from which they were isolated: blue is Acahual (secondary vegetation of tropical forest); orange is under orange tree (Citrus sinensis L.); green is shade house. The analysis was performed by maximum likelihood with bootstrap replicates = 1,000.
Discussion
In this study, only mycorrhizal fungi of the genus Tulasnella were isolated, identified by morphology (hyphae smaller than 4 microns, no polyphenol oxidase activity, non-digitiform monilioid cells, slow growth rates, binucleate cells, submerged growth) and confirmed by molecular identification, in the four cropping systems. Besides observing pelotons with different morphologies, no other genus associated with vanilla such as Ceratobasidium, Thanatephorus, Sebacina and Scleroderma were found, -not even from direct tissue amplifications (Otero et al. 2002, Porras-Alfaro & Bayman 2003, 2007, González-Chávez et al. 2018, Carbajal-Valenzuela et al. 2021).
Conversely, no consistent morphological differences of the colonies grouped in the different clades were found. Except for two isolates (A-V5 and Uo-05), all strains grew faster on PDA than on MEA. Among the strains forming a separate clade, only Sh-01 differs from all isolates in basal septum and hyphal width, and it does not cluster with the rest of isolates in the phylogenetic tree. Hyphal width is a distinguishable feature to separate Epulorhiza anamorphs, with most measuring less than 4 microns or slightly above. Isolate P-06 was significantly smaller than the others, but it did not affect its growth rate or cause it to separate and form a distinct clade with fine hyphal strains. In the case of monilia, only four isolates generated these asexual cells, making it difficult to associate their appearance to phylogeny. Nonetheless, all exhibited characteristics of highly elongated cells, which further differentiate the anamorph Ceratorhiza (Fujimori et al. 2019). This is even though each cultivation system has different management conditions, such as the incorporation of distinct organic matter sources, which could be reflected in the diversity of saprobes in the soil, as mycorrhizal fungi are. A study conducted in three localities in Veracruz, at distances between 0.8, 10, and 32 km from the sites of this research, investigated three different traditional management systems using other tutors (trunks of Gliricidia sepium and Pachira macrocarpa); however, this study did not report any Tulasnella sequences (Johnson et al. 2021). One reason for this could be that they do not isolate the fungi from mycorrhizal structures despite the higher diversity of endophytes sequenced directly from the roots; indeed, most of them are not assigned as mycorrhizal. It is common for the number of molecular species identified in orchids to be several times higher than the number of isolated endophytes, likely because some fungi of the Rhizoctonia genus do not grow in culture media (Bayman & Otero 2006). The genus Tulasnella has also been found to be the most abundant genus in vanilla crops on Reunion Island (Petrolli et al. 2024, Hellequin et al. 2024). However, many orchid genera are known to be associated with specific families of mycorrhizal fungi, such as the terrestrial orchid Cypripedium, which is associated with the family Tulasnellaceae (Moreno-Camarena & Ortega-Larrocea 2022).
This demonstrates that the management system, phorophyte species, and soil nutrients influence the symbionts associated with vanilla (Johnson et al. 2021, Hellequin et al. 2024, Petrolli et al. 2024). It is possible that some fungi coming from crops outside the harvesting site are inoculated already in the soil, as many producers usually buy rooted cuttings from different locations. Instead, fungi can also originate from transplanted or natural soils, depending on the host or phorophyte. In citrus cultivations, plants are introduced to the soil, whereas in traditional management systems, acahual and pichoco tree, most phorophytes are naturally occurring trees from the site. Additionally, many of the mycorrhizal fungi associated with vanilla are genetically similar to those found in tropical orchids worldwide (Nontachaiyapoom et al. 2010).
Vanilla crops are highly susceptible to attacks from fungi of the genus Fusarium because the temperature and humidity that promotes growth also create the ideal conditions for these pathogens’ development, which are among the most abundant soil and root endophytes. However, not all species are necessarily pathogenic or cause symptoms when vanilla plants are healthy (Hernández-Hernández et al. 2010b, Adame-García et al. 2015). In Mexico, F. oxysporum has been reported on vanilla plants in the state of Veracruz (Adame-García et al. 2015, Gónzalez-Reyes et al. 2020), Nayarit (Casillas-Isiordia et al. 2017), and the Huasteca Potosina (Hernández-Martínez et al. 2020, Franco-Galindo & Mosquera-Espinosa 2023). This work identifies at least two species -F. falciforme and F. oxysporum f. sp. vanilla- across different cropping systems. The latter was identified in the acahual (Cuyuxquihui site) and shade house systems, where plants exhibited symptoms of chlorosis, as well as stem and root rot. In the acahual system, the prevalence of the pathogen is linked to inadequate management practices for the control of this disease. This issue is particularly critical in agricultural crops, where management strategies aimed at enhancing plant growth and yield can inadvertently create environmental conditions that favor the emergence and proliferation of pathogenic microorganisms (Dearnaley et al. 2012, Hernández-Hernández et al. 2010b). Control of fungal diseases is therefore carried out by applying different nonspecific fungicides that also affect mycorrhizal fungi populations.
The mycorrhizal genus Tulasnella is the predominant symbiotic genus in four vanilla cropping systems in the totonacapan region, indicating that this plant specifically associates with several species, both globally distributed as well as local to Papantla, Veracruz. This highlights the need for molecular tools to distinguish between potential different species based on their percentage of similarity, even though their mycorrhizal potential does not correlate with their mycorrhization efficiency. The diversity of mycorrhizal fungi associated with orchids is still underexplored, leading to the discovery of more new molecular species encrypted by somatic mycelia (Freitas et al. 2020, Arifin et al. 2022), which have insufficient structural features to identify them (Vilmar et al. 2013, Li et al. 2021). The results offer valuable insights into potential fungal strains adapted to local management conditions, which could be of particular interest in vanilla cultivation and could serve as future research to produce bioinoculants that help increase nutrient availability in commercial vanilla plantations. According to Álvarez-López et al. (2014), rhizospheric microorganisms isolated from vanilla plants have the potential to increase biomass, height, and phosphorus (P) content in vanilla plants (Osorio et al. 2012, Mahadeo et al. 2022). Furthermore, it would be of utmost importance to evaluate their capacity as biological control agents against pathogens such as Fusarium. Although cosmopolitan species were found, both genotypes could be explored as inoculants either prior to transplanting cuttings or directly inoculated into the substrates after mass inoculation. It is necessary to begin this type of research because vanilla cultivation in Mexico is highly significant, not only for its commercial value but also for its importance in its cultural representation (Kourí 2013, Amenta-Montero et al. 2022, Karremans 2022). Consequently, it is crucial to explore ecological alternatives that facilitate the cultivation of organic vanilla.
Given the scenario of climate change, deforestation, loss of traditional knowledge and social issues related to organized crime, vanilla seems to be destined to extinction (Villanueva-Viramontes et al. 2017), so local vanilla producers of vainilla should seek alternatives together with the denomination of origin (DOF 2009) (ancestral connotation) and move towards organic cultivation. This would enable them to have a slogan to face up to its decreased production (Barrera-Rodríguez et al. 2014) as the “Organic SAGARPA Mexico” seal (SENASICA 2025) or the Green Seal, that promotes agro-ecological production (SEDEMA 2025).










nueva página del texto (beta)



